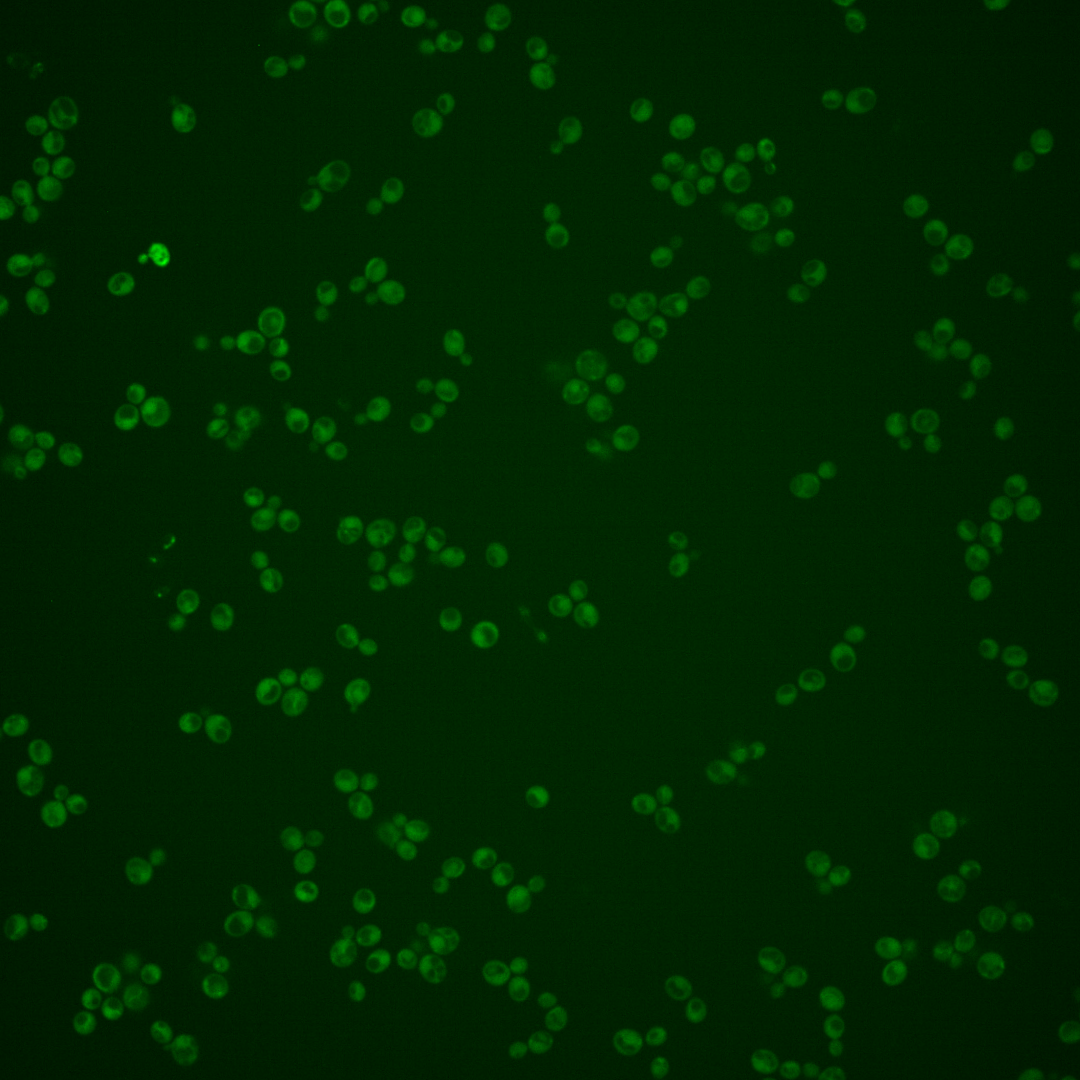
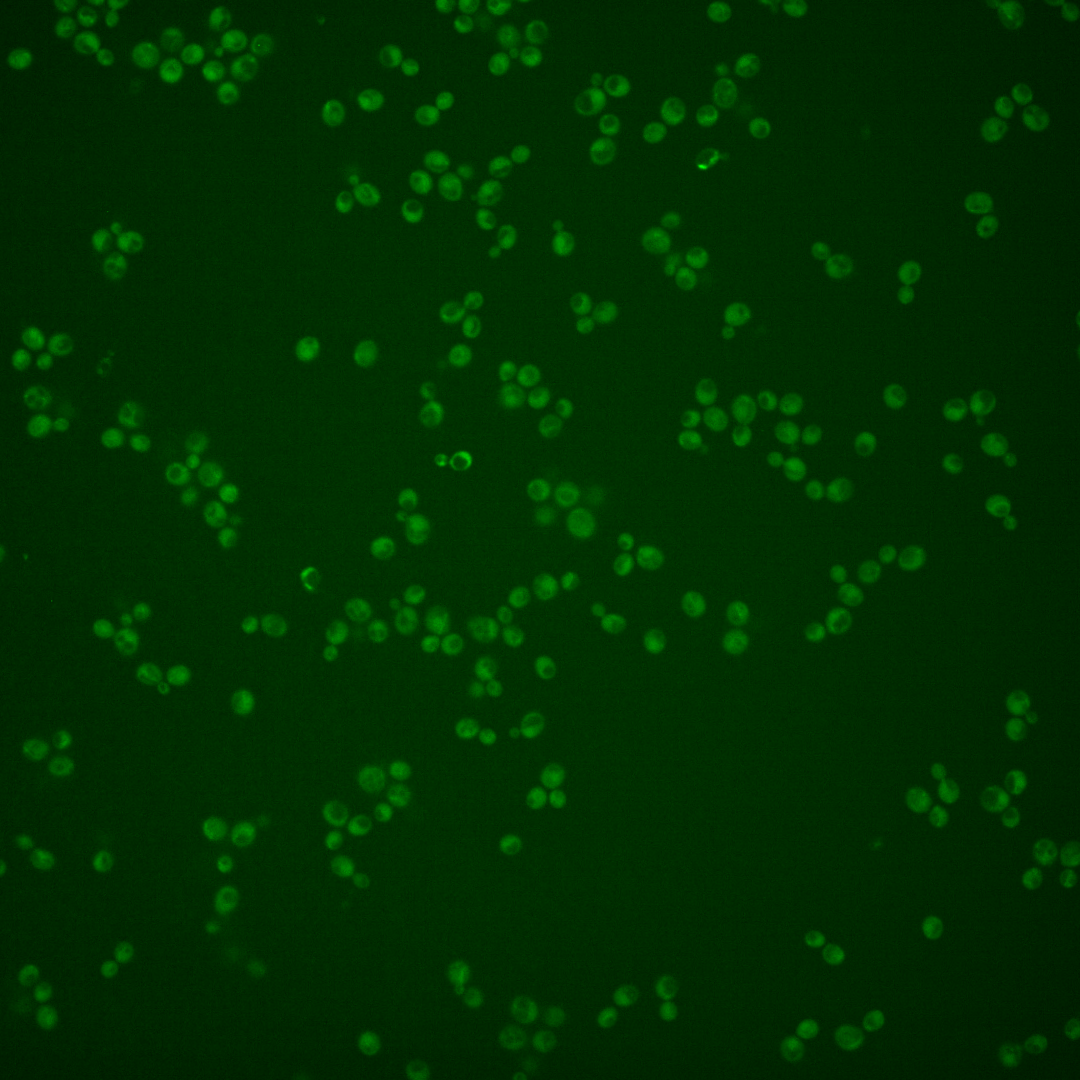
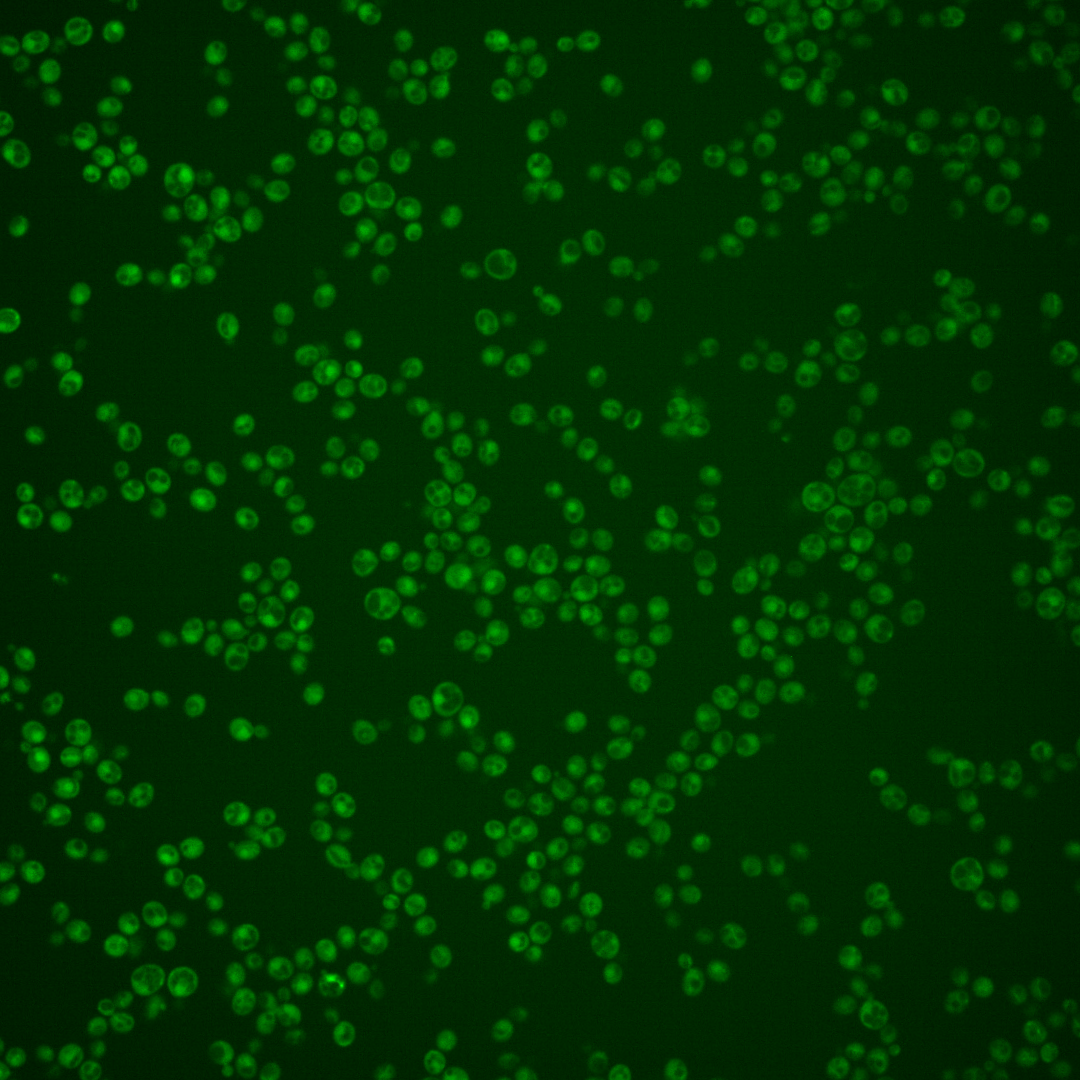
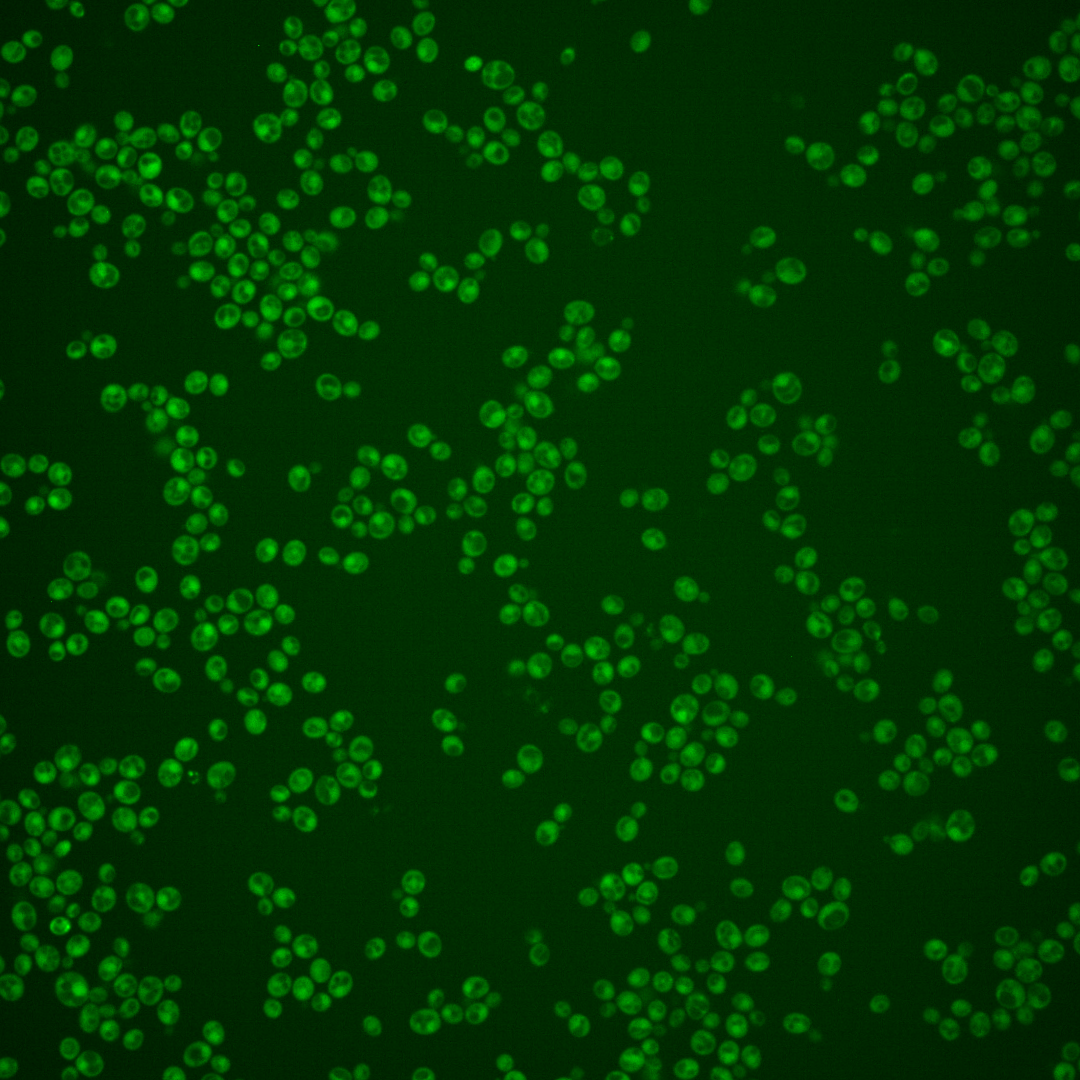
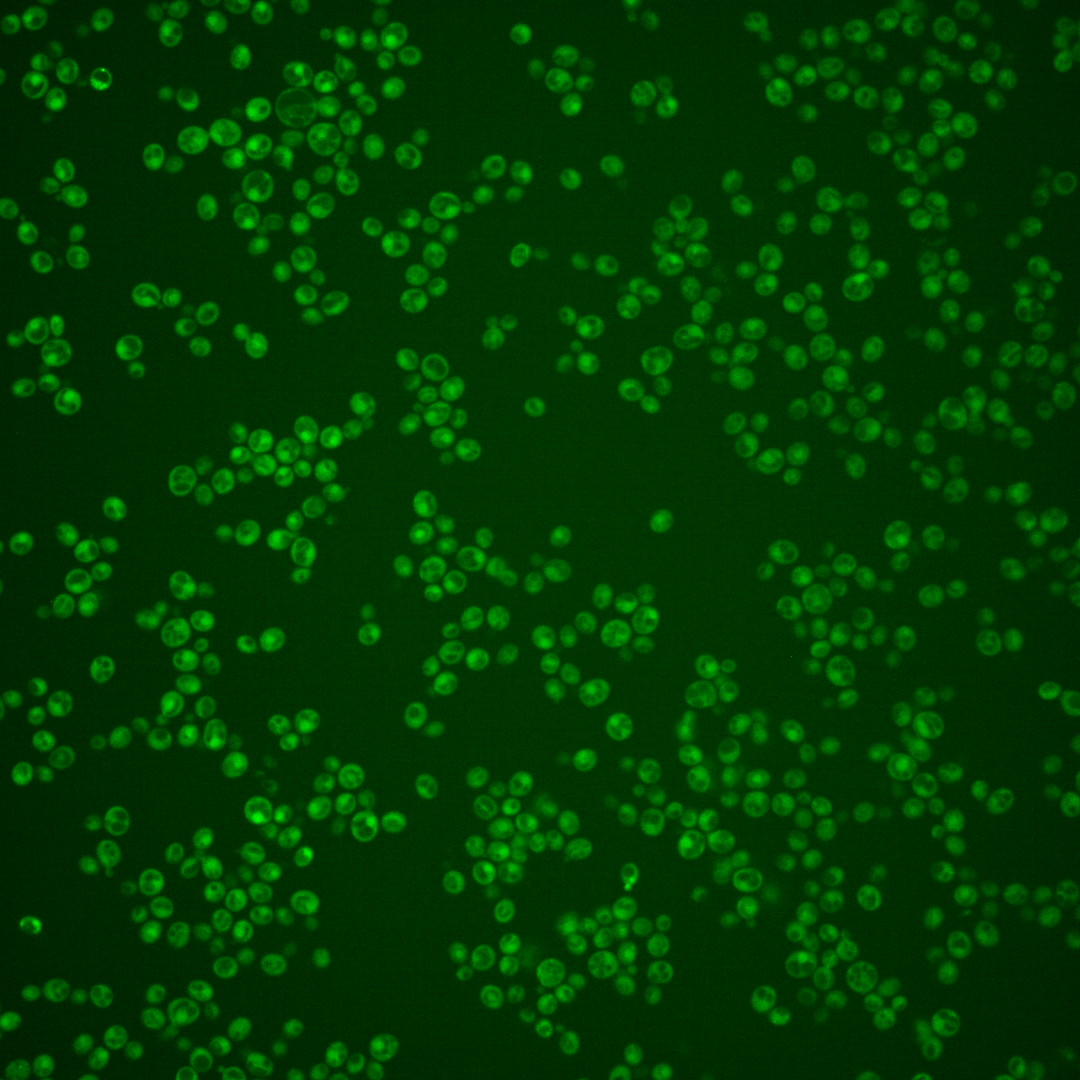

| Standard name | |
|---|---|
| Human Ortholog | |
| Description | Phosphatidylinositol 4-kinase; catalyzes first step in the biosynthesis of phosphatidylinositol-4,5-biphosphate; may control cytokinesis through the actin cytoskeleton; may control nonselective autophagy and mitophagy through trafficking of Atg9p |
Micrographs




















































































Sub-cellular Localization
Yeast GFP Assignment
Protein Abundance
Localization Change
External localization resources
| ensLOC | DeepLoc | |||||||||||||||||||||||
|---|---|---|---|---|---|---|---|---|---|---|---|---|---|---|---|---|---|---|---|---|---|---|---|---|
| Localization | WT1 | WT2 | WT3 | RAP60 | RAP140 | RAP220 | RAP300 | RAP380 | RAP460 | RAP540 | RAP620 | RAP700 | HU80 | HU120 | HU160 | rpd3Δ_1 | rpd3Δ_2 | rpd3Δ_3 | WT1 | WT2 | WT3 | AF100 | AF140 | AF180 |
| Cortical Patches | 1 | 0 | 0 | 0 | 0 | 0 | 0 | 0 | 0 | – | 0 | 0 | 0 | 0 | 0 | – | 0 | 0 | 2 | 3 | 5 | 1 | 3 | 2 |
| Bud | 1 | 1 | 1 | 2 | 1 | 1 | 10 | 2 | 4 | – | 7 | 5 | 0 | 0 | 11 | – | 0 | 1 | 0 | 1 | 0 | 0 | 0 | 3 |
| Bud Neck | 4 | 1 | 1 | 3 | 11 | 4 | 9 | 5 | 3 | – | 7 | 5 | 0 | 0 | 0 | – | 4 | 6 | 0 | 1 | 0 | 0 | 1 | 0 |
| Bud Site | 0 | 0 | 0 | 0 | 0 | 0 | 1 | 1 | 1 | – | 0 | 3 | 0 | 0 | 0 | – | 0 | 0 | – | – | – | – | – | – |
| Cell Periphery | 0 | 1 | 3 | 1 | 3 | 3 | 1 | 3 | 2 | – | 0 | 2 | 0 | 1 | 0 | – | 3 | 3 | 2 | 2 | 4 | 0 | 1 | 1 |
| Cytoplasm | 212 | 250 | 195 | 246 | 311 | 384 | 392 | 461 | 232 | – | 215 | 240 | 150 | 296 | 295 | – | 244 | 388 | 166 | 200 | 103 | 135 | 234 | 245 |
| Endoplasmic Reticulum | 1 | 1 | 0 | 0 | 1 | 0 | 0 | 0 | 0 | – | 0 | 1 | 0 | 10 | 9 | – | 9 | 28 | 1 | 0 | 2 | 0 | 2 | 5 |
| Endosome | 0 | 0 | 0 | 0 | 0 | 0 | 0 | 0 | 0 | – | 0 | 0 | 0 | 0 | 0 | – | 5 | 5 | 3 | 1 | 0 | 0 | 0 | 1 |
| Golgi | 1 | 1 | 0 | 0 | 1 | 0 | 0 | 0 | 0 | – | 0 | 0 | 0 | 0 | 0 | – | 1 | 0 | 1 | 0 | 1 | 1 | 0 | 0 |
| Mitochondria | 3 | 15 | 4 | 14 | 9 | 36 | 68 | 76 | 82 | – | 105 | 153 | 4 | 1 | 5 | – | 5 | 9 | 34 | 24 | 38 | 9 | 9 | 15 |
| Nucleus | 1 | 0 | 0 | 1 | 0 | 0 | 1 | 3 | 0 | – | 0 | 2 | 0 | 1 | 0 | – | 0 | 0 | 0 | 0 | 0 | 0 | 0 | 0 |
| Nuclear Periphery | 0 | 0 | 0 | 0 | 0 | 0 | 1 | 0 | 0 | – | 0 | 3 | 0 | 0 | 0 | – | 0 | 0 | 0 | 0 | 0 | 0 | 0 | 0 |
| Nucleolus | 0 | 0 | 0 | 0 | 0 | 1 | 0 | 2 | 2 | – | 1 | 1 | 0 | 0 | 0 | – | 0 | 1 | 0 | 0 | 0 | 0 | 0 | 0 |
| Peroxisomes | 0 | 0 | 0 | 0 | 0 | 0 | 0 | 0 | 0 | – | 0 | 1 | 0 | 0 | 0 | – | 1 | 0 | 0 | 0 | 0 | 0 | 0 | 0 |
| SpindlePole | 1 | 1 | 0 | 1 | 0 | 0 | 6 | 8 | 4 | – | 5 | 12 | 0 | 0 | 1 | – | 3 | 2 | 3 | 2 | 1 | 1 | 1 | 4 |
| Vac/Vac Membrane | 1 | 2 | 0 | 0 | 0 | 0 | 2 | 0 | 1 | – | 0 | 0 | 0 | 0 | 0 | – | 4 | 7 | 1 | 7 | 2 | 0 | 5 | 6 |
| Unique Cell Count | 218 | 260 | 196 | 249 | 322 | 393 | 425 | 489 | 269 | 271 | 353 | 150 | 306 | 306 | 260 | 404 | 225 | 254 | 172 | 161 | 268 | 292 | ||
| Labelled Cell Count | 226 | 273 | 204 | 268 | 337 | 429 | 491 | 561 | 331 | 340 | 428 | 154 | 309 | 321 | 279 | 450 | 225 | 254 | 172 | 161 | 268 | 292 | ||
Yeast GFP Assignment
Protein Abundance
| Screen | WT1 | WT2 | WT3 | RAP60 | RAP140 | RAP220 | RAP300 | RAP380 | RAP460 | RAP540 | RAP620 | RAP700 | HU80 | HU120 | HU160 | rpd3Δ_1 | rpd3Δ_2 | rpd3Δ_3 | AF100 | AF140 | AF180 |
|---|---|---|---|---|---|---|---|---|---|---|---|---|---|---|---|---|---|---|---|---|---|
| Mean Cell GFP Intensity (1e-4) | 3.9 | 3.1 | 2.9 | 2.6 | 2.9 | 2.6 | 2.5 | 2.7 | 2.2 | – | 2.3 | 2.1 | 3.9 | 4.2 | 3.7 | 4.7 | 5.1 | 5.1 | 3.9 | 3.4 | 4.4 |
| Std Deviation (1e-4) | 0.7 | 0.6 | 0.9 | 0.9 | 0.8 | 0.8 | 1.2 | 1.1 | 1.1 | – | 0.9 | 1.1 | 1.3 | 1.8 | 1.7 | 1.7 | 2.1 | 1.6 | 1.3 | 1.1 | 2.0 |
| Intensity Change (Log2) | – | – | – | -0.12 | 0.01 | -0.13 | -0.17 | -0.1 | -0.35 | – | -0.34 | -0.43 | 0.44 | 0.56 | 0.37 | 0.73 | 0.84 | 0.83 | 0.44 | 0.24 | 0.61 |
Localization Change
| Localization | RAP60 | RAP140 | RAP220 | RAP300 | RAP380 | RAP460 | RAP540 | RAP620 | RAP700 | HU80 | HU120 | HU160 | rpd3Δ_1 | rpd3Δ_2 | rpd3Δ_3 |
|---|---|---|---|---|---|---|---|---|---|---|---|---|---|---|---|
| Actin | – | – | – | – | – | – | – | – | – | – | – | – | – | – | – |
| Bud | – | – | – | – | – | – | – | – | – | – | – | – | – | – | – |
| Bud Neck | – | – | – | – | – | – | – | – | – | – | – | – | – | – | – |
| Bud Site | – | – | – | – | – | – | – | – | – | – | – | – | – | – | – |
| Cell Periphery | – | – | – | – | – | – | – | – | – | – | – | – | – | – | – |
| Cyto | – | – | – | – | – | – | – | – | – | – | – | – | – | – | – |
| Endoplasmic Reticulum | – | – | – | – | – | – | – | – | – | – | – | – | – | – | – |
| Endosome | – | – | – | – | – | – | – | – | – | – | – | – | – | – | – |
| Golgi | – | – | – | – | – | – | – | – | – | – | – | – | – | – | – |
| Mitochondria | – | – | – | – | – | – | – | – | – | – | – | – | – | – | – |
| Nuclear Periphery | – | – | – | – | – | – | – | – | – | – | – | – | – | – | – |
| Nuc | – | – | – | – | – | – | – | – | – | – | – | – | – | – | – |
| Nucleolus | – | – | – | – | – | – | – | – | – | – | – | – | – | – | – |
| Peroxisomes | – | – | – | – | – | – | – | – | – | – | – | – | – | – | – |
| SpindlePole | – | – | – | – | – | – | – | – | – | – | – | – | – | – | – |
| Vac | – | – | – | – | – | – | – | – | – | – | – | – | – | – | – |
| Cortical Patches | – | – | – | – | – | – | – | – | – | – | – | – | – | – | – |
| Cytoplasm | – | – | – | – | – | – | – | – | – | – | – | – | – | – | – |
| Nucleus | – | – | – | – | – | – | – | – | – | – | – | – | – | – | – |
| Vacuole | – | – | – | – | – | – | – | – | – | – | – | – | – | – | – |
External localization resources
Images






























Protein Concentration and Protein Localization Data
| R1 | R2 | R3 | ||||||||||||||||
|---|---|---|---|---|---|---|---|---|---|---|---|---|---|---|---|---|---|---|
| G1 Pre-START | G1 Post-START | S/G2 | Metaphase | Anaphase | Telophase | G1 Pre-START | G1 Post-START | S/G2 | Metaphase | Anaphase | Telophase | G1 Pre-START | G1 Post-START | S/G2 | Metaphase | Anaphase | Telophase | |
| Concentration | 0.2077 | -0.462 | -0.4974 | -0.6731 | -0.9278 | -0.4857 | 1.3716 | 0.7348 | 0.5687 | 0.5939 | 0.8906 | 0.5678 | -0.2438 | 0.2158 | -0.2484 | -0.0151 | -0.2876 | 0.0507 |
| Actin | 0.062 | 0.0008 | 0.0046 | 0.0027 | 0.0009 | 0.0016 | 0.0832 | 0.0002 | 0.0148 | 0.0125 | 0.0297 | 0.0101 | 0.0107 | 0.0001 | 0.0001 | 0.0001 | 0 | 0.0001 |
| Bud | 0.0011 | 0.0008 | 0.0008 | 0.0084 | 0 | 0.0006 | 0.0037 | 0.0001 | 0.0022 | 0.0002 | 0.0016 | 0.0011 | 0.001 | 0.0001 | 0 | 0 | 0 | 0 |
| Bud Neck | 0.0115 | 0.0002 | 0.0032 | 0.004 | 0 | 0.0038 | 0.0091 | 0 | 0.0003 | 0.0002 | 0.0011 | 0.0015 | 0.0008 | 0.0002 | 0 | 0 | 0 | 0 |
| Bud Periphery | 0.0021 | 0.0013 | 0.0018 | 0.0255 | 0.0001 | 0.0023 | 0.0081 | 0.0002 | 0.0097 | 0.0003 | 0.0043 | 0.0046 | 0.0034 | 0.0002 | 0.0001 | 0 | 0 | 0 |
| Bud Site | 0.0124 | 0.003 | 0.0123 | 0.0033 | 0 | 0.0044 | 0.0322 | 0.0002 | 0.0018 | 0.0007 | 0.004 | 0.0006 | 0.0008 | 0.0003 | 0 | 0 | 0 | 0 |
| Cell Periphery | 0.0005 | 0.0002 | 0.0007 | 0.0009 | 0 | 0.0007 | 0.0012 | 0.0001 | 0.0003 | 0.0001 | 0.0003 | 0.0001 | 0.0009 | 0.0005 | 0.0001 | 0 | 0 | 0 |
| Cytoplasm | 0.0125 | 0.038 | 0.0189 | 0.0361 | 0.0056 | 0.0425 | 0.0355 | 0.0584 | 0.0281 | 0.0284 | 0.0721 | 0.0847 | 0.025 | 0.016 | 0.0147 | 0.0103 | 0.0346 | 0.0199 |
| Cytoplasmic Foci | 0.0323 | 0.0368 | 0.0072 | 0.0165 | 0.0012 | 0.0174 | 0.0474 | 0.0054 | 0.0108 | 0.0054 | 0.007 | 0.0137 | 0.0034 | 0.0043 | 0.0019 | 0.0022 | 0.007 | 0.0033 |
| Eisosomes | 0.0007 | 0.0002 | 0.0003 | 0.0003 | 0.0004 | 0.0002 | 0.001 | 0.0001 | 0.0002 | 0.0002 | 0.0004 | 0.0002 | 0.0007 | 0.0003 | 0.0003 | 0.0001 | 0.0001 | 0.0001 |
| Endoplasmic Reticulum | 0.003 | 0.0008 | 0.0005 | 0.0011 | 0 | 0.0002 | 0.0073 | 0.0005 | 0.0011 | 0.0019 | 0.0008 | 0.0016 | 0.0027 | 0.0004 | 0.0003 | 0.0002 | 0.0008 | 0.0003 |
| Endosome | 0.0415 | 0.003 | 0.0026 | 0.0016 | 0 | 0.0003 | 0.0401 | 0.0048 | 0.0123 | 0.0218 | 0.0273 | 0.0092 | 0.0054 | 0.0038 | 0.0005 | 0.0007 | 0.0132 | 0.0035 |
| Golgi | 0.0308 | 0.0005 | 0.0029 | 0.0005 | 0 | 0.0001 | 0.0142 | 0.0002 | 0.0039 | 0.0078 | 0.0106 | 0.0069 | 0.0005 | 0.0001 | 0 | 0 | 0.0001 | 0 |
| Lipid Particles | 0.0367 | 0.0017 | 0.0017 | 0.0012 | 0.0001 | 0.0007 | 0.0348 | 0.0005 | 0.0034 | 0.008 | 0.0247 | 0.0106 | 0.0028 | 0.0006 | 0.001 | 0.0004 | 0.0002 | 0.0003 |
| Mitochondria | 0.0165 | 0.0011 | 0.0052 | 0.0039 | 0.0001 | 0.0002 | 0.0166 | 0.0002 | 0.0192 | 0.0044 | 0.0297 | 0.0083 | 0.0007 | 0.0003 | 0.0001 | 0.0002 | 0.0001 | 0.0001 |
| None | 0.6882 | 0.9037 | 0.9301 | 0.8858 | 0.9911 | 0.9144 | 0.6037 | 0.923 | 0.8588 | 0.9014 | 0.7361 | 0.8195 | 0.9103 | 0.918 | 0.9794 | 0.9843 | 0.9402 | 0.9681 |
| Nuclear Periphery | 0.0052 | 0.0003 | 0.0003 | 0.0005 | 0 | 0.0002 | 0.0166 | 0.0003 | 0.0013 | 0.0028 | 0.0011 | 0.0069 | 0.0045 | 0.0002 | 0.0001 | 0.0002 | 0.0002 | 0.0001 |
| Nucleolus | 0.0017 | 0.0004 | 0.0024 | 0.0013 | 0 | 0.0003 | 0.0011 | 0.0002 | 0.0007 | 0.0001 | 0.0006 | 0.0012 | 0.0023 | 0.0006 | 0.0001 | 0.0001 | 0 | 0.0001 |
| Nucleus | 0.002 | 0.0008 | 0.0006 | 0.0011 | 0 | 0.0008 | 0.0021 | 0.0002 | 0.0016 | 0.0004 | 0.0008 | 0.0029 | 0.0023 | 0.0014 | 0.0001 | 0.0001 | 0.0001 | 0.0003 |
| Peroxisomes | 0.0293 | 0.0036 | 0.0013 | 0.0013 | 0.0002 | 0.0003 | 0.0138 | 0.0002 | 0.0142 | 0.001 | 0.0282 | 0.0036 | 0.0003 | 0.0001 | 0.0001 | 0.0001 | 0 | 0 |
| Punctate Nuclear | 0.006 | 0.0023 | 0.0014 | 0.0011 | 0.0001 | 0.0087 | 0.0193 | 0.0006 | 0.0018 | 0.0011 | 0.0011 | 0.0043 | 0.0107 | 0.0002 | 0.0003 | 0.0002 | 0.0001 | 0.0001 |
| Vacuole | 0.0028 | 0.0006 | 0.001 | 0.0024 | 0 | 0.0003 | 0.0063 | 0.0042 | 0.0125 | 0.0007 | 0.0113 | 0.006 | 0.009 | 0.051 | 0.0007 | 0.0007 | 0.0027 | 0.0033 |
| Vacuole Periphery | 0.0014 | 0.0001 | 0.0002 | 0.0005 | 0 | 0 | 0.0027 | 0.0003 | 0.001 | 0.0006 | 0.0073 | 0.0023 | 0.0017 | 0.0013 | 0 | 0.0001 | 0.0006 | 0.0003 |
Sequencing Data
| R1 | R2 | |||||||||
|---|---|---|---|---|---|---|---|---|---|---|
| G1 Post-START | S/G2 | Metaphase | Anaphase | Telophase | G1 Post-START | S/G2 | Metaphase | Anaphase | Telophase | |
| Gene Expression | 20.1653 | 16.0236 | 16.692 | 25.8125 | 18.7709 | 20.6709 | 27.5736 | 26.1806 | 22.7768 | 28.1858 |
| Translational Efficiency | 0.8187 | 0.8527 | 0.8884 | 0.5358 | 0.8148 | 0.7103 | 0.5448 | 0.4771 | 0.6144 | 0.5484 |
Hit Data
| Dataset | Hit |
|---|---|
| Protein Concentration | ✘ |
| Protein Localization | ✘ |
| Gene Expression | ✘ |
| Translational Efficiency | ✘ |
Endocytosis
| Temp | Actin Patch (Sac6-tdTomato) | Cortical Patch (Sla1-GFP) | Late Endosome (Snf7-GFP) | Vacuole (Vph1-GFP) |
|---|---|---|---|---|
| 37℃ | ||||
| RT |
Cell Cycle Omics
CYCLoPs (Pik1-GFP)
| Gene / Allele | Actin Patch (Sac6-tdTomato) | Cortical Patch (Sla1-GFP) | Late Endosome (Snf7-GFP) | Vacuole (Sac6-tdTomato) |
|---|
| Gene | Images |
|---|
| Gene | Images |
|---|
Images are not yet available
Images are not yet available